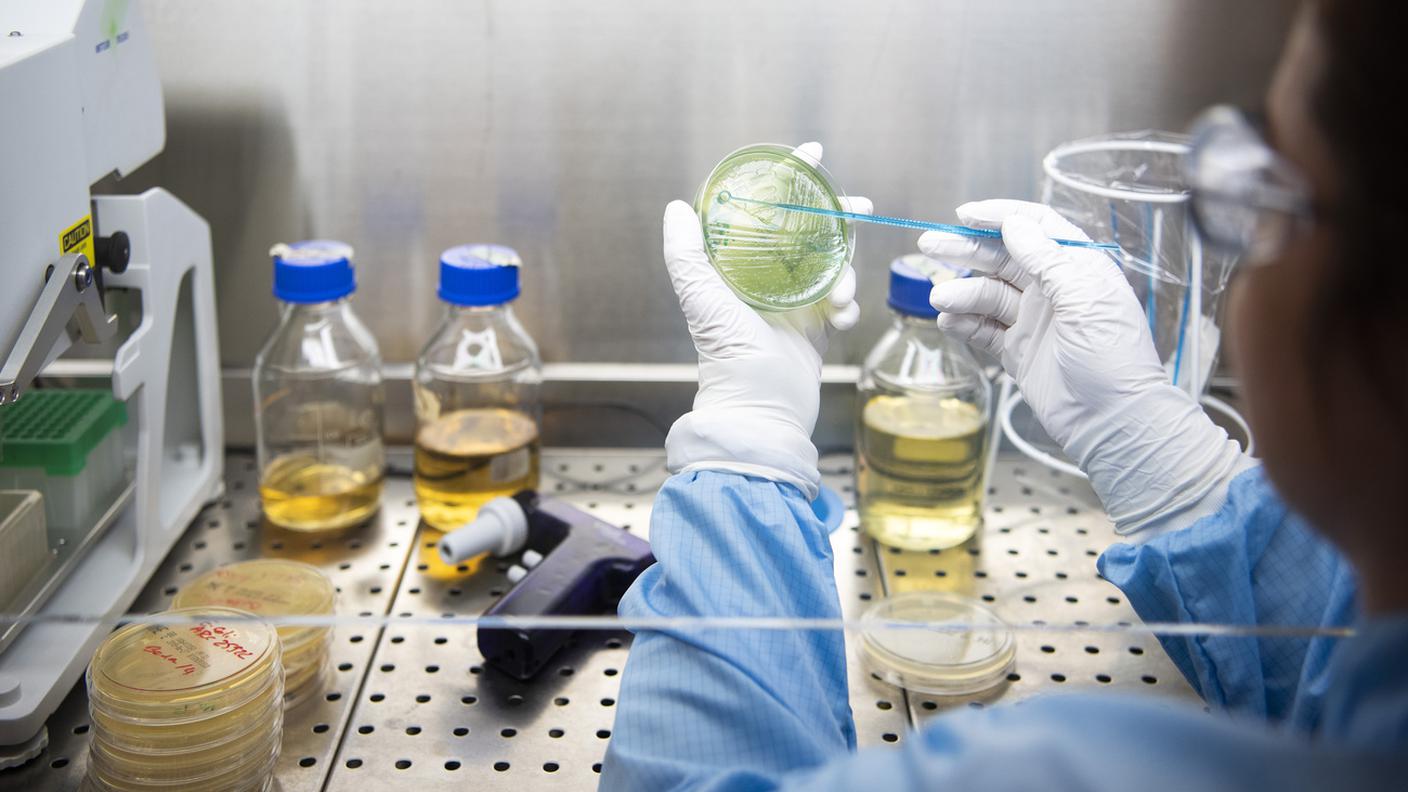
Preoccupazioni maggiori derivano dalle politiche statunitensi per abbassare i prezzi dei farmaci e dai massicci investimenti promessi dall'industria farmaceutica agli USA

Il Tribunale cantonale del canton Berna ha confermato giovedì le condanne per rissa contro sei motociclisti che nel 2019 avevano preso parte a un sanguinoso scontro tra bande rivali di biker a Belp (BE), in cui diverse persone erano rimaste gravemente ferite.
La polizia cantonale bernese ha schierato un grosso contingente fuori dal tribunale per evitare scontri tra i membri dei Bandidos e degli Hells Angels. Ma la situazione è rimasta calma perché non c’erano motociclisti delle bande rivali.
Nel 2022 il Tribunale distrettuale aveva condannato 17 biker delle due bande. Sei di essi hanno intentato ricorso; cinque imputati cui erano state inflitte pene sospese con la condizionale speravano in un’assoluzione, mentre uno in una pena più mite.
In prima istanza la sanzione più pesante, accettata dall’interessato, era stata di otto anni di reclusione per tentato omicidio intenzionale. Un austriaco cui era stata comminata una pena detentiva di tre anni sarà giudicato a parte.
Notiziario 08.00 del 30.06.2022 La corrispondenza di Gian Paolo Driussi
RSI Info 30.06.2022, 10:59
Contenuto audio